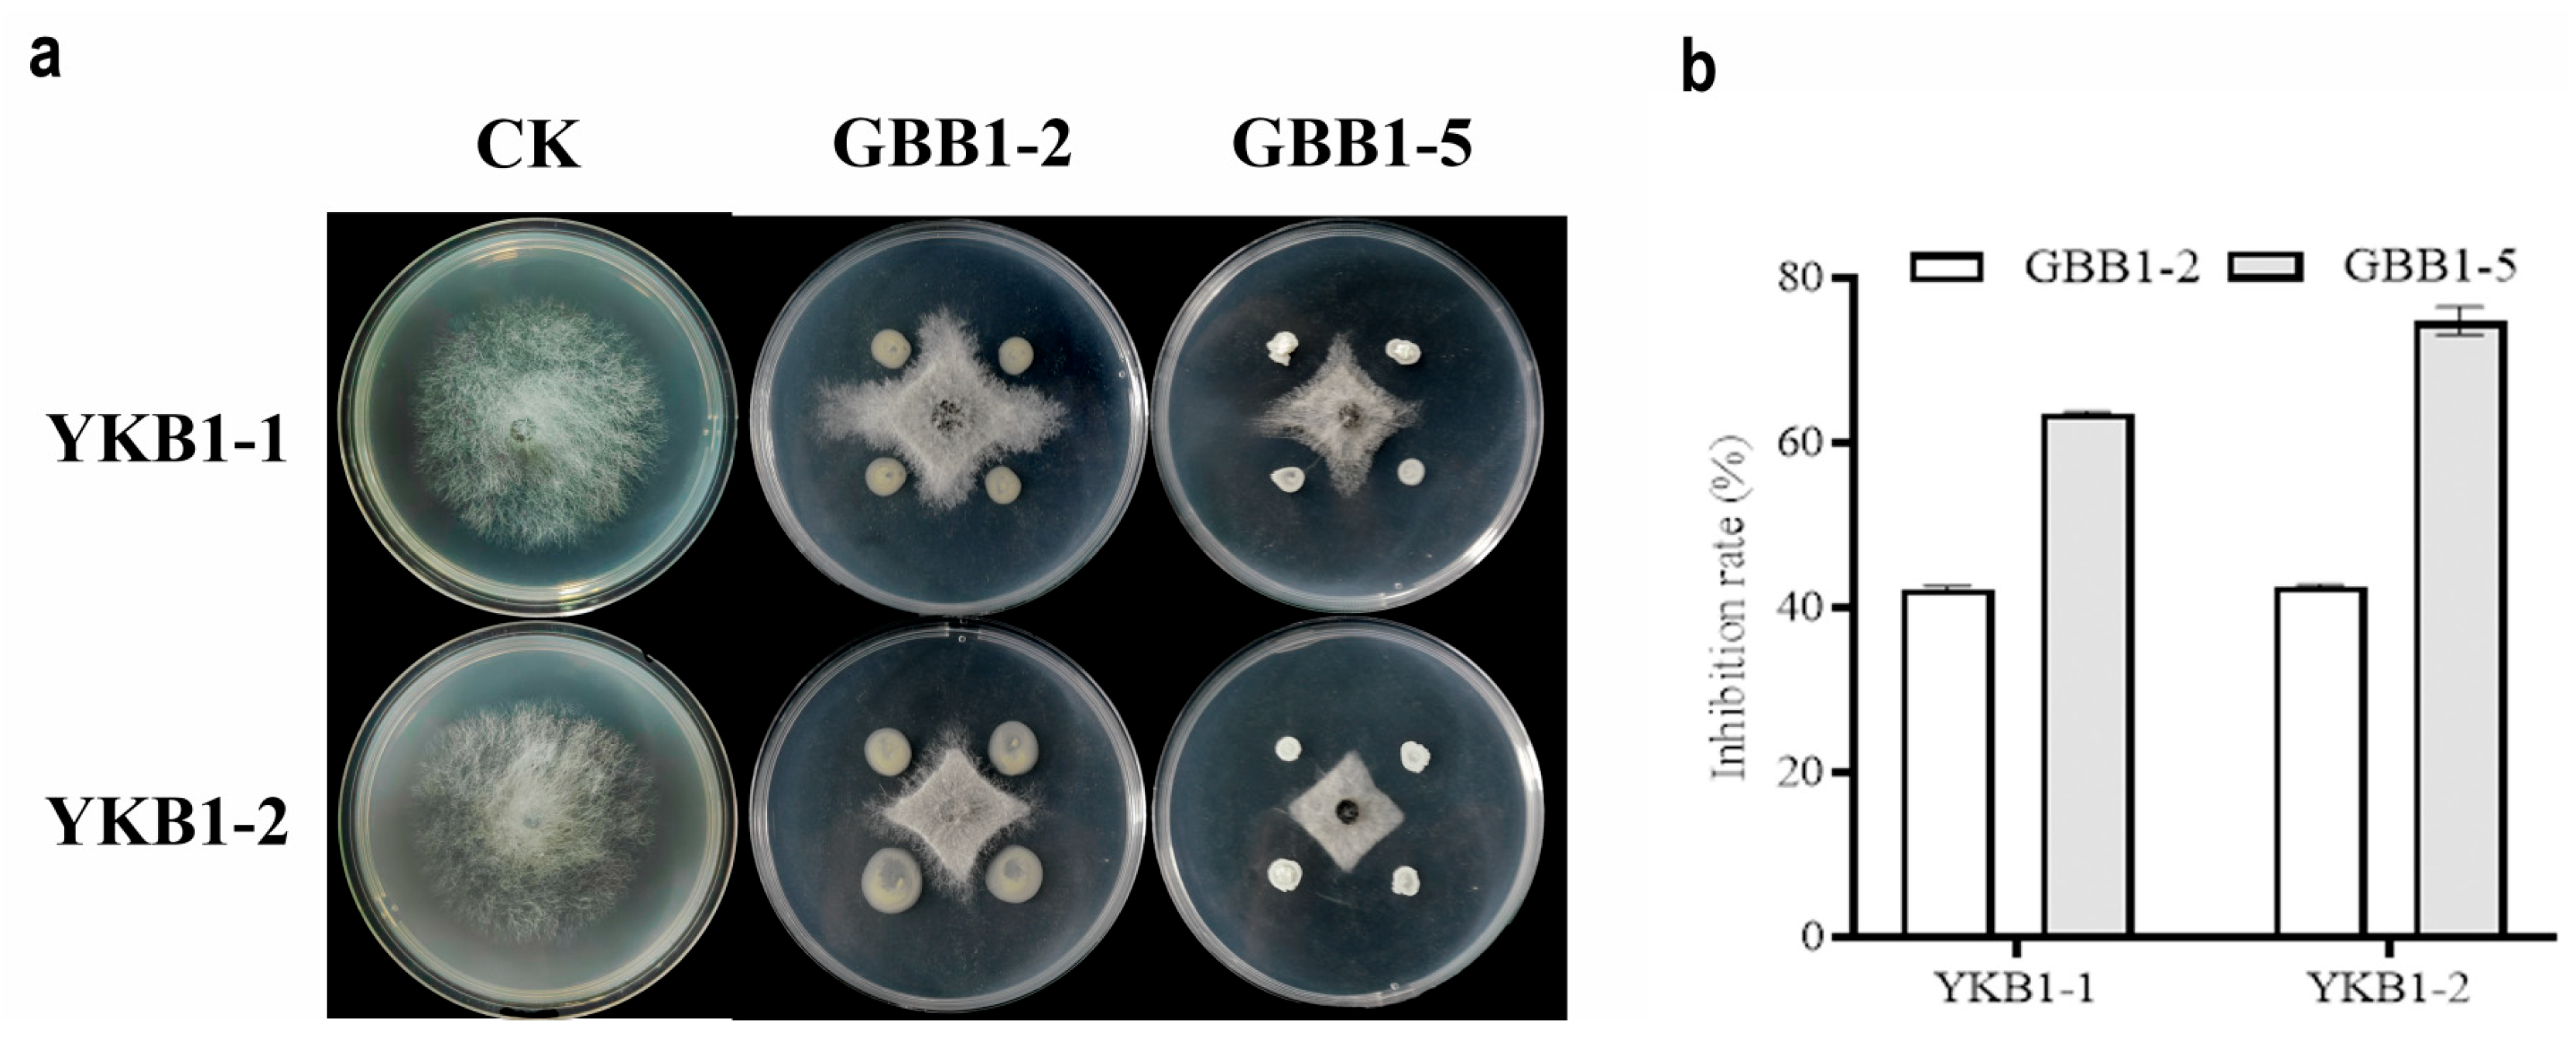
Microorganisms 12 02125 g006

New Occurrence of Nigrospora oryzae Causing Leaf Blight in Ginkgo biloba in China and Biocontrol Screening of Endophytic Bacteria
Abstract
1. Introduction
2. Materials and Methods
2.1. Disease Investigation, Sampling, and Isolation
2.2. Pathogenicity Tests
2.3. Morphological Identification
2.4. DNA Extraction, Amplification, Sequencing, and Phylogenetic Analyses
2.5. Isolation of Endophytic Bacteria from G. biloba Leaves
2.6. Screening for Endophytic Bacteria from G. biloba Leaves
2.7. Molecular Identification of Endophytic Bacteria
3. Results
3.1. Symptoms Observed Under Field Conditions
3.2. Pathogenicity of Fungal Isolates
3.3. Morphological Characteristics of the Pathogens
3.4. Phylogenetic Analyses of the Pathogens
3.5. Screening of Endophytic Bacteria for Biocontrol
3.6. Phylogenetic Analyses of Endophytic Bacteria
4. Discussion
5. Conclusions
Supplementary Materials
Author Contributions
Funding
Data Availability Statement
Conflicts of Interest
References
- You, W.; Zhang, B.; Zhu, L.M.; Xu, M. Occurrence and diagnosis of Ginkgo biloba leaf blight in Nanjing. J. Jiangsu For. Sci. Technol. 2021, 48, 37–40 + 45. [Google Scholar] [CrossRef]
- Chen, Z.S. The value of Ginkgo biloba and its seedling breeding technology. Mod. Agric. Sci. Technol. 2013, 13, 191–192. [Google Scholar] [CrossRef]
- Xia, Y.L.; Shang, Y.C. The value of Ginkgo biloba and its silvicultural management techniques. For. By-Prod. Spec. Chin. 2022, 6, 74–75. [Google Scholar] [CrossRef]
- Shi, J.K.; Fan, W.G.; Wen, X.P. Studies on the morphological differentiation of female flower buds in Ginkgo biloba. Acta Hortic. Sin. 1998, 1, 34–36. [Google Scholar]
- Wang, J.T. Medicinal and edible value of Ginkgo biloba extract. Food Drug 2006, 11, 73–74. [Google Scholar] [CrossRef]
- Wei, C.Y.; Zhang, Y.S.; Zhong, X.B.; Lu, S.S.; Zou, X.Q.; Yang, Y.F.; Huang, S.Q.; Huang, Z.G. Ginkgo biloba leaf extract mitigates cisplatin-induced chronic renal interstitial fibrosis by inhibiting the epithelial-mesenchymal transition of renal tubular epithelial cells mediated by the Smad3/TGF-β1 and Smad3/p38 MAPK pathways. Chin. Med. 2022, 17, 25. [Google Scholar] [CrossRef]
- Hashiguchi, M.; Ohta, Y.; Shimizu, M.; Maruyama, J.; Mochizuki, M. Meta-analysis of the efficacy and safety of Ginkgo biloba extract for the treatment of dementia. J. Pharm. Health Care Sci. 2015, 1, 14. [Google Scholar] [CrossRef]
- Tan, Q.; Yang, G.; Ma, H.; Luo, L. Research on the factors affecting the extraction of polysaccharides from Ginkgo leaves. Med. Chem. Res. 2021, 8, 137–138. [Google Scholar] [CrossRef]
- Wang, Y.H.; An, J.W.; Zhao, Y.W. Current status and development strategies of Ginkgo variety resources in Jiangsu Province. J. Zhejiang Agric. Sci. 2008, 5, 550–553. [Google Scholar] [CrossRef]
- Wang, M.; Liu, F.; Crous, P.W.; Cai, L. Phylogenetic reassessment of Nigrospora: Ubiquitous endophytes, plant and human pathogens. Persoonia 2017, 39, 118–142. [Google Scholar] [CrossRef]
- Zimmerman, A. Ueber einige an tropischen Kulturpflanzen beobachtete Pilze III. Zentralblatt Für Bakteriol. Parasitenkunde. 1902, 8, 216–221. [Google Scholar]
- Chen, S. Identification of the pathogen of Nigrospora oryzae leaf spot of sugarcane, measurement of its effects on the physiological and biochemical characteristics of sugarcane seedlings and screening of fungicides against the pathogen. Fujian Agric. For. Univ. 2020, 23, 1–2. [Google Scholar] [CrossRef]
- Yang, B. Biodiversity studies on genus and species of soil dematiaceous hyphomycetes from Guizhou Province of China. Guizhou Univ. 2010, 8, 59–61. [Google Scholar] [CrossRef]
- Chen, Y.; Yang, X.; Zhang, A.F.; Zang, H.Y.; Gu, C.Y.; Hameed, U.; Qi, Y.J.; Xu, Y.L. First report of leaf spot caused by Nigrospora sphaerica on kiwifruit in China. Plant Dis. 2016, 100, 2326–2327. [Google Scholar] [CrossRef]
- Kwon, Y.; Kim, M.; Kwack, Y.B.; Kwak, Y.S. First report of Nigrospora sp. causing kiwifruit postharvest black rot. N. Z. J. Crop Hortic. Sci. 2017, 45, 75–79. [Google Scholar] [CrossRef]
- Petrovic, E.; Vrandecic, K.; Cosic, J.; Dermic, E.; Godena, S. First report of Nigrospora species causing leaf spot on olive (Olea europaea L.). Horticulturae 2023, 9, 1067. [Google Scholar] [CrossRef]
- Han, Y.Z.; Fan, Z.W.; Wu, C.F.; Li, M.Y.; Zhou, D.D. First report of Nigrospora leaf blight on elephant grass caused by Nigrospora sphaerica in China. Plant Dis. 2019, 103, 2681–2682. [Google Scholar] [CrossRef]
- Kee, Y.J.; Hafifi, A.B.M.; Huda-Shakirah, A.R.; Wong, K.L.; Jin, X.L.; Nordahliawate, M.S.S.; Zakaria, L.; Mohd, M.H. First report of reddish brown spot disease of red-fleshed dragon fruit (Hylocereus polyrhizus) caused by Nigrospora lacticolonia and Nigrospora sphaerica in Malaysia. Crop Prot. 2019, 122, 165–170. [Google Scholar] [CrossRef]
- Tong, J.; Zhang, X.; Li, J.; Zhang, F. Advances in chemical constituents and bioactivities of Nigrospora sp. fungi. Nat. Prod. Res. 2022, 34, 1618–1631. [Google Scholar] [CrossRef]
- Dhevi, V.S.R.; Arunachalam, S. Endophytic fungi of Tradescantia pallida mediated targeting of Multi-Drug resistant human pathogens. Saudi J. Biol. Sci. 2024, 31, 103937. [Google Scholar] [CrossRef]
- Fei, D.; Tan, G.; Luo, D. Identification and characterization of rice spikelet rot disease pathogens in Anhui Province. J. Anhui Agric. Univ. 2014, 41, 777–782. [Google Scholar] [CrossRef]
- Li, X.; Fu, H.; Li, H. Biological characterization and fungicide screening of Nigrospora oryzae. J. Chang. Veg. 2016, 6, 80–84. [Google Scholar]
- Hao, F.; Zhou, G.Y.; Li, H. Progress of identification methods of economical plant pathogenic fungi. Nonwood For. Res. 2009, 27, 112–116. [Google Scholar] [CrossRef]
- Wang, X.; Ren, X.; Yang, H.; He, B.; Deng, Y.; Zhou, Q. Isolation and identification of the pathogen causing rice leaf stripes in Daoxian County of Hunan Province. Biol. Disaster Sci. 2024, 47, 28–33. [Google Scholar] [CrossRef]
- Saikkonen, K.; Faeth, S.H.; Helander, M.; Sullivan, T.J. Fungal endophytes: A continuum of interactions with host plants. Annu. Rev. Ecol. Syst. 1998, 29, 319–343. [Google Scholar] [CrossRef]
- Aly, A.H.; Debbab, A.; Proksch, P. Fungal endophytes: Unique plant inhabitants with great promises. Appl. Microbiol. Biotechnol. 2011, 90, 1829–1845. [Google Scholar] [CrossRef]
- Bacon, C.W.; White, J.F. Microbial Endophytes; Marcel Dekker Inc.: New York, NY, USA, 2000. [Google Scholar]
- Rodriguez, R.; Redman, R. More than 400 million years of evolution and some plants still can’t make it on their own: Plant stress tolerance via fungal symbiosis. J. Exp. Bot. 2008, 59, 1109–1114. [Google Scholar] [CrossRef]
- Alam, B.; Li, J.W.; Ge, Q.; Khan, M.A.; Gong, J.W.; Mehmood, S.; Yuan, Y.L.; Gong, W.K. Endophytic fungi: From symbiosis to secondary metabolite communications or vice versa? Front. Plant Sci. 2021, 12, 791033. [Google Scholar] [CrossRef]
- Alavanja, M.C.; Hoppin, J.A.; Kamel, F. Health effects of chronic pesticide exposure: Cancer and neurotoxicity. Annu. Rev. Public Health 2004, 25, 155–197. [Google Scholar] [CrossRef]
- Chen, X.; Rechavi, O. Plant and animal small RNA communications between cells and organisms. Nat. Rev. Mol. Cell Biol. 2022, 23, 185–203. [Google Scholar] [CrossRef]
- Luo, K.; Wang, G.P.; Huang, S.Y. Study on rice round spot disease. J. Hum. Agric. Univ. 1987, 01, 59–68. [Google Scholar] [CrossRef]
- Liu, L. Occurrence and control measures of rice fever disease. Seed Sci. Technol. 2024, 42, 127–129. [Google Scholar] [CrossRef]
- Iida, Y.; Ogata, A.; Kanda, H.; Nishi, O.; Sushida, H.; Higashi, Y.; Tsuge, T. Biocontrol activity of nonpathogenic strains of Fusarium oxysporum: Colonization on the root surface to overcome nutritional competition. Front. Microbiol. 2022, 13, 826677. [Google Scholar] [CrossRef]
- Chen, J. Research on microecological characteristics and green remediation measures of continuous cropping tobacco root system. Shandong Agric. Univ. 2022, 22, 14–16. [Google Scholar] [CrossRef]
- Palmieri, D.; Ianiri, G.; Del Grosso, C.; Barone, G.; De Curtis, F.; Castoria, R.; Lima, G. Advances and perspectives in the use of biocontrol agents against fungal plant diseases. Horticulturae 2022, 8, 577. [Google Scholar] [CrossRef]
- Bai, H. Efficacy evaluation of Bacillus subtilis EBS03 on control of cotton Verticillium wilt and optimization of culture conditions. Xinjiang Agric. Univ. 2022, 23, 3–6. [Google Scholar] [CrossRef]
- O’Sullivan, D.J.; O’Gara, F. Traits of fluorescent Pseudomonas spp. involved in suppression of plant root pathogens. Microbiol. Rev. 1992, 56, 662–676. [Google Scholar] [CrossRef]
- Thiruvengadam, R.; Gandhi, K.; Vaithiyanathan, S.; Sankarasubramanian, H.; Loganathan, K.; Lingan, R.; Rajagopalan, V.R.; Muthurajan, R.; Ebenezer Iyadurai, J.; Kuppusami, P. Complete genome sequence analysis of Bacillus subtilis Bbv57, a promising biocontrol agent against phytopathogens. Int. J. Mol. Sci. 2022, 23, 9732. [Google Scholar] [CrossRef]
- Meena, M.; Swapnil, P.; Divyanshu, K.; Kumar, S.; Harish; Tripathi, Y.N.; Zehra, A.; Marwal, A.; Upadhyay, R.S. PGPR-mediated induction of systemic resistance and physiochemical alterations in plants against the pathogens: Current perspectives. J. Basic Microbiol. 2020, 60, 828–861. [Google Scholar] [CrossRef]
- Sempere, F.; Santamarina, M.P. Suppression of Nigrospora oryzae (Berk. & Broome) Petch by an aggressive mycoparasite and competitor, Penicillium oxalicum Currie & Thom. Int. J. Food Microbiol. 2008, 122, 35–43. [Google Scholar] [CrossRef]
- Sturz, A.V.; Christie, B.; Nowak, J. Bacterial endophytes: Potential role in developing sustainable systems of crop production. Crit. Rev. Plant Sci. 2000, 19, 1–30. [Google Scholar] [CrossRef]
- Yang, R.; Tao, Y.; Song, M.; Hu, F. Inhibition of endophytic bacterial strains isolated from Ginkgo biloba against Phytophthora blight of pepper. Chin. J. Biol. Control 2012, 28, 552–559. [Google Scholar] [CrossRef]
- Freeman, S.; Katan, T.; Shabi, E. Characterization of Colletotrichum gloeosporioides isolates from avocado and almond fruits with molecular and pathogenicity tests. Appl. Environ. Microbiol. 1996, 62, 1014–1120. [Google Scholar] [CrossRef] [PubMed]
- White, T.J.; Bruns, T.; Lee, S.J.W.T.; Taylor, J. Amplification and direct sequencing of fungal ribosomal RNA genes for phylogenetics. In PCR Protocols: A Guide to Methods and Applications; Innis, M.A., Gelfand, D.H., Sninsky, J.J., Eds.; Academic Press: Cambridge, MA, USA, 1990; pp. 315–322. [Google Scholar]
- Carbone, I.; Kohn, L.M. A method for designing primer sets for speciation studies in filamentous ascomycetes. Mycologia. 1999, 91, 553–556. [Google Scholar] [CrossRef]
- Glass, N.L.; Donaldson, G.C. Development of primer sets designed for use with the PCR to amplify conserved genes from filamentous ascomycetes. Appl. Environ. Microbiol. 1995, 61, 1323–1330. [Google Scholar] [CrossRef]
- Katoh, K.; Standley, D.M. MAFFT multiple sequence alignment software version 7: Improvements in performance and usability. Mol. Biol. Evol. 2013, 30, 772–780. [Google Scholar] [CrossRef]
- Hall, T.A. BioEdit: A user-friendly biological sequence alignment editor and analysis program for windows 95/98/NT. Nucleic Acids Symp. Ser. 1999, 41, 95–98. [Google Scholar] [CrossRef]
- Kalyaanamoorthy, S.; Minh, B.Q.; Wong, T.K.F.; von Haeseler, A.; Jermiin, L.S. ModelFinder: Fast model selection for accurate phylogenetic estimates. Nat. Methods 2017, 14, 587–589. [Google Scholar] [CrossRef]
- von Haeseler, A.; Schmidt, H.A.; Nguyen, L.T.; Minh, B.Q. IQ-TREE: A fast and effective stochastic algorithm for estimating maximum-likelihood phylogenies. Mol. Biol. Evol. 2015, 32, 268–274. [Google Scholar] [CrossRef]
- Peng, Q.J. Isolation and screening of endophytic antagonistic bacteria from tea leaves and research on biocontrol potentials. Guizhou Univ. 2022, 20, 21–22. [Google Scholar] [CrossRef]
- Islam, S.; Akanda, A.M.; Prova, A.; Islam, M.T.; Hossain, M.M. Isolation and identification of plant growth promoting rhizobacteria from cucumber rhizosphere and their effect on plant growth promotion and disease suppression. Front. Microbiol. 2016, 6, 1360. [Google Scholar] [CrossRef] [PubMed]
- Xie, Z.H.; Gao, J.; Wang, J.Y.; Peng, X.X.; Tang, X.K.; Wang, H.H. Isolation and identification of an antagonistic bacterium against Rhizoctonia solani, the causing agent of rice sheath blight. Microbiol. China 2012, 39, 477–485. [Google Scholar] [CrossRef]
- Weisburg, W.G.; Barns, S.M.; Pelletier, D.A.; Lane, D.J. 16S ribosomal DNA amplification for phylogenetic study. J. Bacteriol. 1991, 173, 697–703. [Google Scholar] [CrossRef] [PubMed]
- Zhai, J.C.; Leng, P.; Gao, S.; Liu, Y.G.; Cui, A.H.; Su, G.A. Stem rot of Ginkgo biloba occurrence pattern and integrated control. Plant Health Med. 2015, 28, 11–12. [Google Scholar] [CrossRef]
- Li, Y.P.; Zhang, L.H.; Tang, Q.; Liu, Y.J. First Report of Trichothecium roseum Causing Trunk Disease of Ginkgo biloba in China. Plant Dis. 2016, 100, 1234–1235. [Google Scholar] [CrossRef]
- Su, X.J.; Shi, R.R.; Li, X.B.; Yu, Z.N.; Hu, L.F.; Hu, H.Y.; Zhang, M.; Chang, J.L.; Li, C.W. Friend or foe? The endophytic fungus Alternaria tenuissima might be a major latent pathogen involved in Ginkgo leaf blight. Forests 2023, 14, 1452. [Google Scholar] [CrossRef]
- Jing, Z.Q.; Guo, Z.J.; Xu, S.J.; He, S.Q. Screening, identification as Bacillus amyloliquefaciens strain HZ6-3 and evaluation of inhibition activity against tomato gray mold, of a bacterial isolate. Acta Prataculturae Sin. 2020, 29, 31–41. [Google Scholar] [CrossRef]
- Sun, M.Q.; Ye, S.H.; Xu, Z.C.; Wan, L.; Zhao, Y.G. Endophytic Bacillus altitudinis Q7 from Ginkgo biloba inhibits the growth of Alternaria alternata in vitro and its inhibition mode of action. Biotechnol. Biotechnol. Equip. 2021, 35, 880–894. [Google Scholar] [CrossRef]
- Yu, S.T. Study on black spot of Hibiscus mutabilis and biocontrol effect of its endogenous bacteria. Sichuan Agric. Univ. 2022, 24, 32–34. [Google Scholar] [CrossRef]
- Abednego, R.; Silago, V. Antibacterial activity of soil-isolated Bacillus altitudinis/pumilus complex against methicillin-resistant Staphylococcus aureus from Mwanza, Tanzania. Afr. J. Lab. Med. 2023, 12, 2167. [Google Scholar] [CrossRef]
- Zeng, Q.C.; Xie, J.B.; Li, Y.; Gao, T.T.; Zhang, X.; Wang, Q. Comprehensive genomic analysis of the endophytic Bacillus altitudinis strain GLB197, a potential biocontrol agent of grape downy mildew. Front. Genet. 2021, 12, 726903. [Google Scholar] [CrossRef]

| Isolate | DNA Target | GenBank Accession No. |
|---|---|---|
| YKB1-1 | ITS | PQ047485 |
| EF1-α | PQ065936 | |
| β-tub | PQ057798 | |
| YKB1-2 | ITS | PQ047486 |
| EF1-α | PQ065937 | |
| β-tub | PQ057799 | |
| GBB1-2 | 16s rDNA | PQ044816 |
| GBB1-5 | 16s rDNA | PQ044817 |
| Species | Isolates | Host | Locality | GenBank Accession Number | ||
|---|---|---|---|---|---|---|
| ITS | β-tub | EF1-α | ||||
| N. aurantiaca | CGMCC 3.18130 * | Nelumbo sp. (leaf) | China | KX986064 | KY019465 | KY019295 |
| LC 7034 | Musa paradisiaca | China | KX986093 | KY019598 | KY019394 | |
| N. bambusae | LC 7244 | Bamboo (leaf) | China | KY385306 | KY385320 | KY385314 |
| LC 7245 | Bamboo (leaf) | China | KY385305 | KY385321 | KY385315 | |
| N. camelliae-sinensis | LC 3287 | Camellia sinensis | China | KX985975 | KY019502 | KY019323 |
| LC 3496 | Camellia sinensis | China | KX985985 | KY019510 | KY019327 | |
| N. chinensis | LC 2696 | Lindera aggregata | China | KX985947 | KY019474 | KY019424 |
| LC 3085 | Camellia sinensis | China | KX985970 | KY019497 | KY019427 | |
| LC 3175 | Camellia sinensis | China | KX985972 | KY019499 | KY019428 | |
| N. hainanensis | LC 7031 | Musa paradisiaca (leaf) | China | KX986092 | KY019597 | KY019417 |
| LC 7042 | Musa paradisiaca (leaf) | China | KX986094 | KY019599 | KY019418 | |
| N. guilinensis | LC 7301 | Nelumbo sp. (stem) | China | KX986063 | KY019608 | KY019404 |
| N. lacticolonia | LC 7009 | Musa paradisiaca (leaf) | China | KX986087 | KY019594 | KY019454 |
| N. musae | LC 6385 | Camellia sinensis | China | KX986042 | KY019567 | KY019371 |
| N. oryzae | LC 2708 | Rhododendron sp. | China | KX985955 | KY019482 | KY019308 |
| LC 3695 | Osmanthus fragrans | China | KX985988 | KY019512 | KY019329 | |
| LC 4265 | Rhododendron sp. | China | KX985994 | KY019518 | KY019335 | |
| LC 5181 | Pentactina rupicola | China | KX986032 | KY019554 | KY019359 | |
| LC 5243 | Submerged wood | China | KX986033 | KY019555 | KY019360 | |
| LC 5965 | Submerged wood | China | KX986038 | KY019560 | KY019364 | |
| N. osmanthi | LC 4487 | Hedera nepalensis | China | KX986017 | KY019540 | KY019438 |
| N. pyriformis | LC 2688 | Lindera aggregata | China | KX985941 | KY019468 | KY019297 |
| LC 2690 | Rosa sp. | China | KX985943 | KY019470 | KY019298 | |
| N. sphaerica | LC 7304 | Nelumbo sp. (leaf) | China | KX986066 | KY019610 | KY019406 |
| LC 2705 | Rosa sp. | China | KX985952 | KY019479 | KY019305 | |
| LC 2839 | Harpullia longipetala | China | KX985964 | KY019491 | KY019317 | |
| LC 5966 | Submerged wood | China | KX986039 | KY019561 | KY019365 | |
| LC 6294 | Camellia sinensis | China | KX986044 | KY019565 | KY019369 | |
| N. vesicularis | LC 0322 | Unknown host plant | Thailand | KX985939 | KY019467 | KY019296 |
| N. zimmermanii | CBS 290.62 * | Saccharum officinarum (leaf) | Ecuador | KY385309 | KY385317 | KY385311 |
| CBS 984.69 | Saccharum officinarum (leaf) | Brazil | KY385310 | KY385322 | KY385316 | |
| Apiospora vietnamensis | KUMCC 21-0429 | Bats | China | ON426827 | OR025929 | OR025968 |
| Species | Isolate | GenBank Accession Number |
|---|---|---|
| Bacillus altitudinis | T7 | OR285258 |
| Bacillus atrophaeus | JCM 9070 | NR024689 |
| Bacillus halotolerans | DSM 8802 | NR115063 |
| Bacillus licheniformis | ATCC 14580 | NR074923 |
| Bacillus mojavensis | IFO 15718 | NR024693 |
| Bacillus nakamurai | NRRL B 41091 | NR151897 |
| Bacillus nematocida | B16 | NR115325 |
| Bacillus siamensis | KCTC 13613 | NR 117274 |
| Bacillus subtilis | IAM 12118 | NR112116 |
| Bacillus vallismortis | DSM 11031 | NR024696 |
| Species | Isolate | GenBank Accession Number |
|---|---|---|
| Bacillus amyloliquefaciens | HN3 | MK310270 |
| L70 | OR841377 | |
| CAU X1 | OQ561751 | |
| HNS S9 | PP087014 | |
| Bacillus atrophaeus | CNEB8 | MZ485377 |
| LZH-J14 | MW474831 | |
| LZH-T4 | OL662992 | |
| Bacillus cereus | B-001 | KT981877 |
| Escherichia coli | K-12 | LT899983 |
Disclaimer/Publisher’s Note: The statements, opinions and data contained in all publications are solely those of the individual author(s) and contributor(s) and not of MDPI and/or the editor(s). MDPI and/or the editor(s) disclaim responsibility for any injury to people or property resulting from any ideas, methods, instructions or products referred to in the content. |
© 2024 by the authors. Licensee MDPI, Basel, Switzerland. This article is an open access article distributed under the terms and conditions of the Creative Commons Attribution (CC BY) license (https://creativecommons.org/licenses/by/4.0/).
Share and Cite
Tao, Y.; Yang, C.; Yu, S.; Fu, F.; Dai, T. New Occurrence of Nigrospora oryzae Causing Leaf Blight in Ginkgo biloba in China and Biocontrol Screening of Endophytic Bacteria. Microorganisms 2024, 12, 2125. https://doi.org/10.3390/microorganisms12112125
Tao Y, Yang C, Yu S, Fu F, Dai T. New Occurrence of Nigrospora oryzae Causing Leaf Blight in Ginkgo biloba in China and Biocontrol Screening of Endophytic Bacteria. Microorganisms. 2024; 12(11):2125. https://doi.org/10.3390/microorganisms12112125
Chicago/Turabian StyleTao, Yuan, Chun Yang, Sinong Yu, Fangfang Fu, and Tingting Dai. 2024. "New Occurrence of Nigrospora oryzae Causing Leaf Blight in Ginkgo biloba in China and Biocontrol Screening of Endophytic Bacteria" Microorganisms 12, no. 11: 2125. https://doi.org/10.3390/microorganisms12112125
APA StyleTao, Y., Yang, C., Yu, S., Fu, F., & Dai, T. (2024). New Occurrence of Nigrospora oryzae Causing Leaf Blight in Ginkgo biloba in China and Biocontrol Screening of Endophytic Bacteria. Microorganisms, 12(11), 2125. https://doi.org/10.3390/microorganisms12112125

